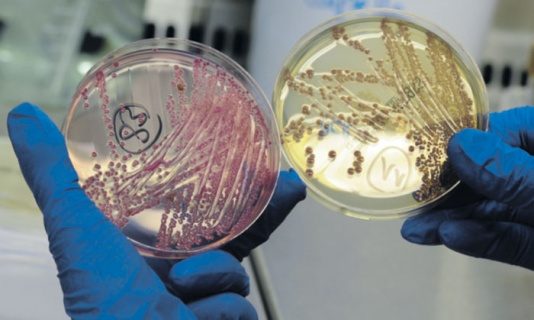

Гигантские вирусы - подарок от Пандоры
Вирусами в Древнем Риме называли грубых легионеров, а также сильных и решительных мужчин – отсюда знаменитые триумвираты («троемужия») и вираго, или мужеподобные женщины. Поначалу сам Луи Пастер называл вирусами открытые им возбудители заболеваний, но потом немец Роберт Кох предложил кокки и бактерии.

Обнаруженные вирусы были сопоставимы по размерам с кишечной палочкой E. coli.
Европа того времени бредила Марсом и открытыми на нем «каналами», отражением чего стала революционно-романтическая «Аэлита», написанная Алексеем Толстым. Неудивительно, что известный химик Сванте Аррениус, нобелевский лауреат 1903 года, предложил коллегам гипотезу панспермии, или распространения спор жизни в космосе. Уже в наше время ее поддержал Френсис Крик, один из авторов открытия двойной спирали ДНК.
Журнал Science в прошлом году опубликовал статью международной группы ученых из университетов Марселя и Гренобля, а также шведской Упсалы, описавших свойства и геномы двух гигантских вирусов. Их назвали в честь Пандоры, богини всеобщего раздора, из ящика которой вылетали всяческие беды. Новые вирусы были выделены из солоноватой воды устья чилийской реки Tunqueen (Pandoravirus salinus) и пресноводного пруда в окрестностях Мельбурна (P. dulcius).
Интерес ученых к находкам был связан с тем, что пандоравирусы ничем не напоминали представителей всех известных вирусных семейств, в том числе и открытых с десяток лет назад мимивирусов (Mimivirus). Последние имеют размер чуть ли не в микрон, сопоставимый с мелкими кокками и той же кишечной палочкой E. coli. Поражали воображение мимивирусы и своим сложным геномом, состоящим из более чем тысячи генов (тот же ВИЧ имеет всего лишь с десяток генов). Потом такие гигантские вирусы, которые стали называть мегавиридами, нашли в самых разных водных источниках по всему миру, но пандоравирусы стоят особняком.
Размер последних превышает микрон (микрометр), что позволяет видеть их в обычный микроскоп. В электронный же микроскоп ученые увидели сложное овоидное (яйцеобразное) строение вирусных частиц P. salinus, имеющих оболочку из трех слоев, каждая из которых толщиной 20–25 нанометров. Средняя оболочка состоит из нитей-фибрилл, а сам овоид имеет хорошо видную пору, через которую выходит в клетку инфицируемой амебы его гигантская ДНК длиной почти в 2,5 млн «букв» ген-кода (нуклеотидов). Для сравнения можно привести геном E. coli, который не превышает 4,5 млн. Можно также отметить, что число генов, кодирующих у P. salinus белки, составляет 2,5 тыс. (2556), что сопоставимо с числом таких генов у микробов. У австралийского вируса геном чуть-чуть не дотянул до 2 млн (1,9 с 1502 генами). Как и мимивирусы, новооткрытые поражают «тернистых» амеб Acanthoamoeba, названных так по их «акантусам», или терновым колючкам на поверхности.
В комментариях на публикацию особо подчеркивается, что пандоравирусы безопасны для человека, поскольку они не «приспособлены» атаковать наши клетки (у вирусов для этого нет молекулярных «девайсов» для подключения к белкам клеточной мембраны-оболочки). Но их в принципе можно снабдить молекулами поверхностных контактов, что может представлять интерес с точки зрения развития генной терапии. О двух удачных разработках сообщил недавно тот же Science.
Речь идет об использовании ген-модифицированных лентивирусов – «ленивых», к коим относится и ВИЧ, – в геном которых сотрудники миланского института Телетон вмонтировали гены ферментов. Мутации в этих генах вызывают врожденный иммунодефицит и дистрофию – распад белого вещества мозга. В обоих случаях вирусные терапии помогли спасти шесть детей (по трое с каждым из заболеваний). Проблема широкого внедрения таких терапий связана с ничтожными размерами используемых сегодня вирусов, в геном которых трудно ввести нужный ген. Хочется надеяться, что открытие мими- и пандоравирусов со временем облегчит задачу геномщиков.
Напомним, что наш геном представлен отцовским и материнским набором хромосом. У амеб, например той же инфузории-туфельки, число копий может достигать тысяч, если не больше. Неудивительно, что и вирусы у них такие гигантские (размер имеет значение). Так что марсианские байки про панспермию имеют вполне земные корни.
Обнаруженные вирусы были сопоставимы по размерам с кишечной палочкой E. coli.
Европа того времени бредила Марсом и открытыми на нем «каналами», отражением чего стала революционно-романтическая «Аэлита», написанная Алексеем Толстым. Неудивительно, что известный химик Сванте Аррениус, нобелевский лауреат 1903 года, предложил коллегам гипотезу панспермии, или распространения спор жизни в космосе. Уже в наше время ее поддержал Френсис Крик, один из авторов открытия двойной спирали ДНК.
Журнал Science в прошлом году опубликовал статью международной группы ученых из университетов Марселя и Гренобля, а также шведской Упсалы, описавших свойства и геномы двух гигантских вирусов. Их назвали в честь Пандоры, богини всеобщего раздора, из ящика которой вылетали всяческие беды. Новые вирусы были выделены из солоноватой воды устья чилийской реки Tunqueen (Pandoravirus salinus) и пресноводного пруда в окрестностях Мельбурна (P. dulcius).
Интерес ученых к находкам был связан с тем, что пандоравирусы ничем не напоминали представителей всех известных вирусных семейств, в том числе и открытых с десяток лет назад мимивирусов (Mimivirus). Последние имеют размер чуть ли не в микрон, сопоставимый с мелкими кокками и той же кишечной палочкой E. coli. Поражали воображение мимивирусы и своим сложным геномом, состоящим из более чем тысячи генов (тот же ВИЧ имеет всего лишь с десяток генов). Потом такие гигантские вирусы, которые стали называть мегавиридами, нашли в самых разных водных источниках по всему миру, но пандоравирусы стоят особняком.
Размер последних превышает микрон (микрометр), что позволяет видеть их в обычный микроскоп. В электронный же микроскоп ученые увидели сложное овоидное (яйцеобразное) строение вирусных частиц P. salinus, имеющих оболочку из трех слоев, каждая из которых толщиной 20–25 нанометров. Средняя оболочка состоит из нитей-фибрилл, а сам овоид имеет хорошо видную пору, через которую выходит в клетку инфицируемой амебы его гигантская ДНК длиной почти в 2,5 млн «букв» ген-кода (нуклеотидов). Для сравнения можно привести геном E. coli, который не превышает 4,5 млн. Можно также отметить, что число генов, кодирующих у P. salinus белки, составляет 2,5 тыс. (2556), что сопоставимо с числом таких генов у микробов. У австралийского вируса геном чуть-чуть не дотянул до 2 млн (1,9 с 1502 генами). Как и мимивирусы, новооткрытые поражают «тернистых» амеб Acanthoamoeba, названных так по их «акантусам», или терновым колючкам на поверхности.
В комментариях на публикацию особо подчеркивается, что пандоравирусы безопасны для человека, поскольку они не «приспособлены» атаковать наши клетки (у вирусов для этого нет молекулярных «девайсов» для подключения к белкам клеточной мембраны-оболочки). Но их в принципе можно снабдить молекулами поверхностных контактов, что может представлять интерес с точки зрения развития генной терапии. О двух удачных разработках сообщил недавно тот же Science.
Речь идет об использовании ген-модифицированных лентивирусов – «ленивых», к коим относится и ВИЧ, – в геном которых сотрудники миланского института Телетон вмонтировали гены ферментов. Мутации в этих генах вызывают врожденный иммунодефицит и дистрофию – распад белого вещества мозга. В обоих случаях вирусные терапии помогли спасти шесть детей (по трое с каждым из заболеваний). Проблема широкого внедрения таких терапий связана с ничтожными размерами используемых сегодня вирусов, в геном которых трудно ввести нужный ген. Хочется надеяться, что открытие мими- и пандоравирусов со временем облегчит задачу геномщиков.
Напомним, что наш геном представлен отцовским и материнским набором хромосом. У амеб, например той же инфузории-туфельки, число копий может достигать тысяч, если не больше. Неудивительно, что и вирусы у них такие гигантские (размер имеет значение). Так что марсианские байки про панспермию имеют вполне земные корни.
Только зарегистрированные и авторизованные пользователи могут оставлять комментарии.

